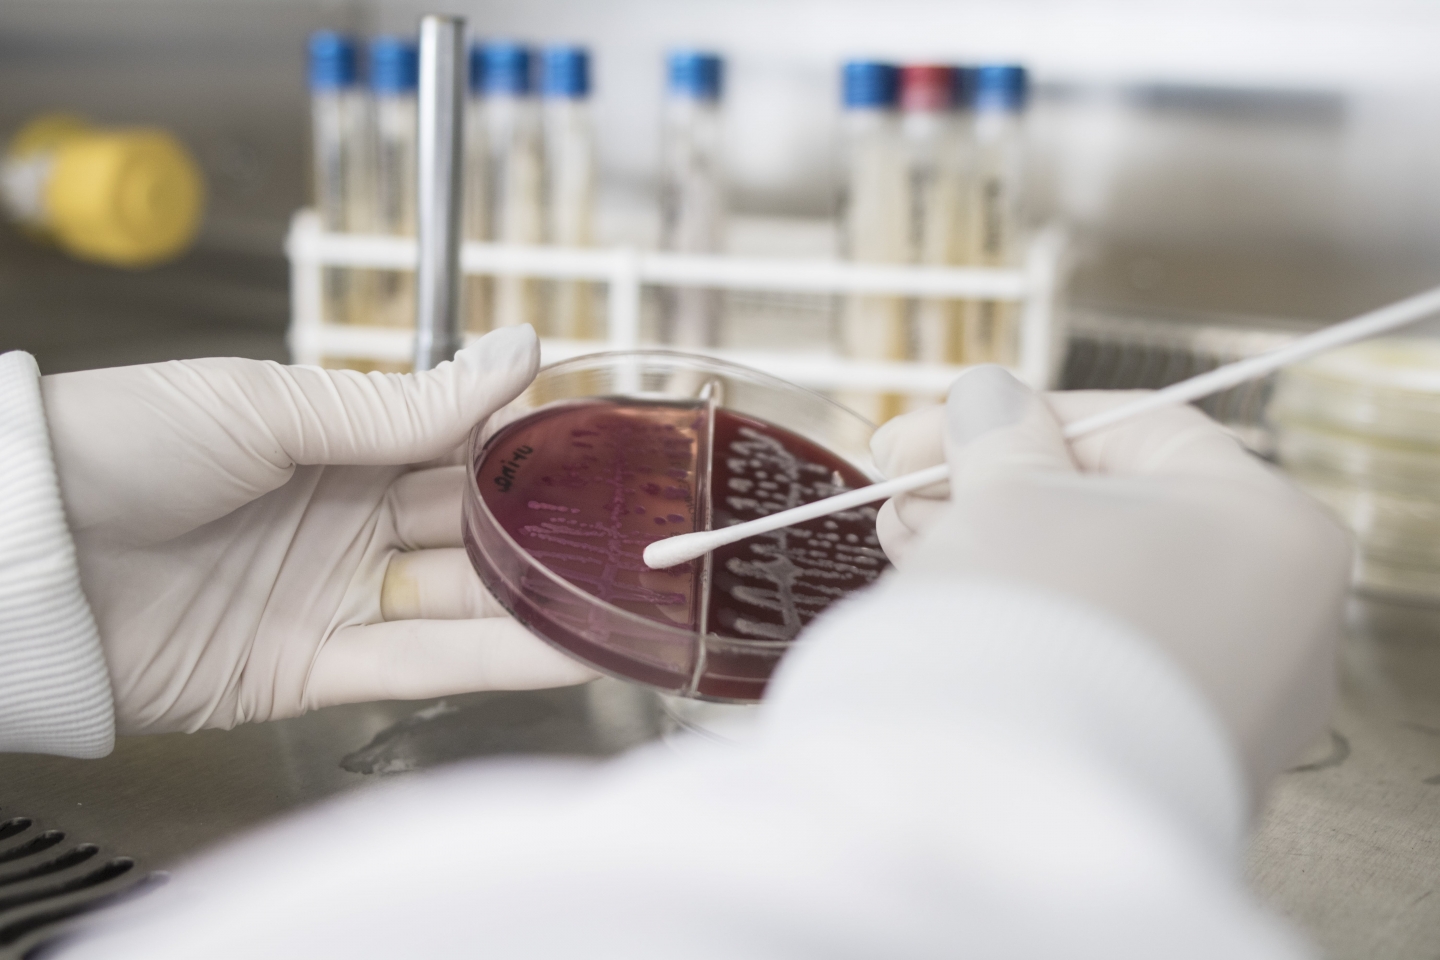

Biomedicina
Curso de Graduação Bacharelado
- Presencial
- Noturno
- 4 anos e meio
Avaliação MEC
- Presencial
- Noturno
- 4.50 anos
Avaliação MEC
Vagas limitadas
Opções de pagamentoDo DNA à vida
Acreditamos no cuidado, no diagnóstico de excelência e na pesquisa clínica para melhorar a vida das pessoas.
Por meio de matriz inovadora e multidisciplinar, aliando técnica e humanização,
formamos profissionais com consciência e responsabilidade social voltadas para a saúde e competentes para qualificar os serviços de diagnóstico.

Sua carreira profissional
O mercado de trabalho do biomédico está em expansão, oferecendo oportunidades nos setores público e privado, além da pesquisa e docência. O diplomado pela Univates pode trabalhar com análises clínicas, análises de imagens, toxicologia, reprodução humana, genética molecular, que abrange pesquisas com células-tronco e exames de DNA, e na área da estética.
Opções de pagamento
Obtenha mais informações sobre as condições de pagamento para este curso.
Formas de ingresso

Vestibular on-line
Para ingressar em um curso de graduação da Univates, você pode fazer sua prova sem sair de casa pela internet, escolhendo o melhor dia e horário para realizá-la. Exceto medicina.
Ingresso via Enem
Se você realizou a prova do Enem a partir do ano de 2009, pode usar a sua nota da redação para ingressar na Univates. Para medicina, o ingresso é exclusivo pela nota do Enem e você pode usar a sua nota a partir do ano de 2017.
Nota da prova de redação realizada na Univates
Se você realizou o vestibular da Univates em algum semestre a partir do ano de 2000, pode usar a sua nota da Redação para ingressar nos cursos. Exceto medicina.
Ingresso com histórico escolar de instituição de ensino superior
Os diplomados ou estudantes de Instituição de Ensino Superior que desejam ingressar nos cursos da Univates poderão, por seleção simplificada, anexar seu histórico de graduação no sistema para análise das notas. Neste histórico é necessário que apareça a nota do processo seletivo de ingresso no referido curso. Exceto medicina.
Quer estudar na Univates?
faça sua inscriçãoCom quem você vai aprender

Geórgia Muccillo Dexheimer
Docente
LattesProfessora na Univates desde 2017. Gosta muito de compartilhar conhecimento, experiências e conversar. Também é professora de violino e piano. Mãe do Arthur, adora estar com a família, com os cachorros e curtir em casa.


Andréa Horst
Docente
LattesBiomédica, doutora em Fisiologia, mãe da Manu e do Be. Ama estudar e adora um desafio na área da saúde.

Fernanda Rocha Da Trindade
Docente
LattesMãe atípica da Laura, noiva, rockeira, colorada e ama vira-latas (temos 5). Gosta de séries, shows, pilates e crossfit. Espumante brut, vinho e IPA são suas bebidas preferidas, além de água com gás e café! Adora uma conversa acompanhada de sorrisos!

Gabriela Kniphoff Da Silva Lawisch
Docente
LattesSonhadora e realista, mãe da Duda e do Gui, ama estar em família! Adora uma praia, uma viagem, um chima, um livro, e uma boa conversa! E adora estar em sala de aula também!

Jairo Luís Hoerlle
Docente
LattesEscuta as pessoas com facilidade. Marido da Margot e pai da Gabriela, curte muito momentos em família. Curioso desde a infância, sempre quis saber o porquê das coisas pela lógica da ciência. Organizado, colecionador por natureza e marceneiro por hobby. O mais importante: por tudo, agradece a Deus.

Vanessa Prass
Docente
LattesBiomédica com 12 anos de experiência em Estética. Especialista em Neurociências e Comportamento e mestre em Neurociências. Curiosa por entender os processos biológicos, culturais e evolutivos que nos fazem perceber beleza no mundo.

Vanderlei Biolchi
Docente
LattesUma cara introspectivo, tímido, que não sabe receber elogios, que some no dia do seu aniversário, porém, em sala de aula, põem a vestimenta de ator e baixa algumas entidades para dar uma boa aula.

Janine Giovanella
Docente
LattesSempre em movimento, é alguém que não consegue ficar parado por muito tempo. Com energia para dar e vender, está sempre buscando novos desafios. Tem um coração enorme, sempre disposto a ajudar e ouvir quem precisa, mas não se engane pela simpatia, quando é hora de ser firme sabe impor limites.

Glademir Schwingel
Docente
LattesProfessor, fisioterapeuta, alguns me consideram um sósia de Robin Williams, o ator. Gosto da ideia, até por que foi um grande artista, com vários trabalhos memoráveis. Talvez já tenham me visto correr por aí, devagar e sempre. Correr é uma prática indispensável, pois movimento é vida. Viajar, ler, s

Maristela Juchum
Docente
LattesAdoro viajar para conhecer novos lugares, mas também curto viajar sem sair de casa, sentada no sofá e assistindo a um bom filme ou lendo um livro de literatura. Sou do tipo natureba, gosto de produtos integrais e amo frutas da estação.

Danieli Gerhardt
Docente
LattesApaixonada pelo mundo! Viajar é sua maior alegria, uma oportunidade de explorar novos horizontes e descobrir o que cada canto do planeta tem de especial. Provar comidas, drinks, é uma aventura à parte. E, claro, ela também adora um bom meme! Especialmente, aqueles que ensinam com leveza e diversão.

Rogério José Schuck
Docente
LattesAmante da música, gosta de acompanhar no contrabaixo uma roda de gaita e violão, ainda mais no complemento de um bom churrasco e uma boa cerveja. Nas aulas e orientações, pesquisa e produção intelectual trabalha com firmeza, porém sem perder a ternura jamais.


Elisete Maria De Freitas
Docente
LattesProfessora, bióloga e pesquisadora apaixonada pela sala de aula e por plantas, vivendo o dia a dia em prol da preservação ambiental por meio do equilíbrio entre todos os elementos da Natureza, do qual somos parte.

Juliana Paula Bruch Bertani
Docente
LattesÉ necessário seriedade em certas atividades da rotina, mas uma pitada de bom humor e descontração são essenciais na vida desta professora. Adoro estar com a família, sentir um abraço apertado e um beijo melecado dos meus filhos. Conversar, viajar, aproveitar o momento, o tempo passa muito rápido.

Samuel Martim De Conto
Docente
LattesFora da rotina acadêmica, adoro passar tempo com minha família, especialmente brincando e me divertindo com meu filho. Sou apaixonado por futebol e não resisto a um bom filme ou série. Procure levar uma vida de forma leve e equilibrada, valorizando os pequenos momentos que fazem toda a diferença.

André Jasper
Docente
LattesSou Professor, Licenciado em Ciências Biológicas e Biólogo Paleontólogo. Amo as Ciências Biológicas, principalmente a paleobotânica e a história evolutiva da biodiversidade ao longo do tempo profundo. Para saber mais, acesso o meu CV Lattes, cujo link está acima. Abraço e nos vemos por aí!

Luís Fernando Da Silva Laroque
Docente
LattesSou um profissional com formação na área da História, gosto da natureza, das diversidades culturais e espero contribuir com tua formação profissional.

Fabrício De Saibro
Docente

Rosiene Almeida Souza Haetinger
Docente
LattesAlém de amar os livros - a ponto de a estante não dar mais conta -, gosto de tudo que envolve cultura e arte: cinema, séries, teatro, música, artes visuais... E o melhor é unir tudo isso ao viajar, conhecer um novo lugar e a cultura local.

Maurício Fernando Nunes Teixeira
Docente
LattesPai da Manoela, Helena e Cecília, gosto muito de música, gastronomia e vinhos. Fã de heavy metal, churrasco e tintos. Tenho poucos amigos, porém muito fiéis. Minha principal terapia é estar em contato com a natureza.


Guilherme Da Costa
Docente
LattesMestre em Ciências Médicas; Biomédico Imagenologista; Especialista em Imagenologia; Professor Medicina e Biomedicina.

Sofia Royer Moraes
Docente
LattesEngenheira, professora, amante das artes, das diversidades culturais, do ambiente e da mística da vida, profe que adora uma boa planilha! Sofia é curiosa e motivada pela vivência de novos desafios, principalmente aqueles que agregam o cuidado com a natureza e o bem-estar de comunidades e cidades.

Gabriela Kaufmann
Docente
Ama aprender e compartilhar o que descobre pelo caminho. Adora estar na natureza e praticar esportes. Valoriza momentos simples, boas conversas, risadas e o tempo com a família e os amigos. Gosta de estar cercada de pessoas, trocar ideias e viver experiências com significado.

Lucélia Hoehne
Docente
LattesAdoro aprender as novidades com essa juventude e sou muito curiosa. Sempre estou pronta para novos desafios!! E de malas prontas para viagens!! Nas horas livres gosto de fazer exercícios físicos (academia, caminhada, dança). Ah!! Amo olhar para as estrelas!!

Ana Emília Klein
Docente
LattesGosta muito de literatura, Chico Buarque e de fazer listas que nunca terminam. Frequenta clubes de leitura e cinema, porque acredita que boas histórias sempre rendem boas conversas. Tem uma gata chamada Cedilha, que não sabe de gramática, mas ensinou que aprender é prestar atenção no mundo.


Ivan Cunha Bustamante Filho
Docente
LattesSou médico veterinário que há 20 anos estuda biologia da reprodução animal, básica e aplicada. Trago essa experiência para as minhas aulas. Além disso, sou um pouco fotógrafo, músico, gira-mundo, pai, filho e irmão.

Pietro Cunha Dolci
Docente
LattesOla, O professor Pietro adora ler, ver filmes e seriados. Ele adora viajar com a familia e conhecer novos lugares. Acredita que estudar seja essencial e necessário para o desenvolvimento dos alunos e sociedade. Publicou um livro Poohpai sobre as atividades e propostas que fez com a filha.

Jamile Wayne Ferreira
Docente
LattesA Jamile é professora de Gastronomia e mestre em Educação. Atualmente pesquisa no doutorado sobre os saberes culinários das mulheres de classes populares, pensando uma Gastronomia descolonizada. Cozinhar e escrever são suas atividades favoritas, mas também adora praia e olhar o céu!

Franciele Zardo
Docente
LattesFranciele, ela é organizada, sistemática, gosta de animais, de ouvir um bom rock e preocupada com o bem estar das pessoas ao seu redor!

Gabriela Da Cruz Campelo
Docente
aula+
a graduaçãoda Univates

Reinvenção do ensino
A nova graduação da Univates une a qualidade de uma das melhores universidades privadas do Brasil a uma proposta curricular inovadora e exclusiva. Os cursos são divididos em blocos curriculares, que integram as vivências do ensino presencial e a flexibilidade do ensino a distância.
Mais qualidade
O programa de ensino foi concebido pelos mestres e doutores da nossa Universidade, organizados em diferentes grupos de trabalho. De forma colaborativa, garantem a articulação entre os componentes dos blocos curriculares.
Mais flexibilidade
O estudante não precisa vir para a Univates todos os dias da semana em que tiver aula. A proposta híbrida é única e cada curso de graduação presencial pode ser composto de até 40% da carga horária na modalidade a distância.
Mais vivências
Os ateliers e seminários serão realizados na Univates, promovendo a interação constante entre estudantes e professores. As atividades práticas continuarão acontecendo em modernos laboratórios, equipados com alta tecnologia.
Mais dinâmica
A partir dos princípios da Aula+, os estudantes contam com formação de excelência e cada vez mais voltada às demandas do mercado de trabalho contemporâneo e ao desenvolvimento regional.
Deseja saber mais? Visite a página do Aula+
Acesse aquiVeja também
Disciplinas
Saiba o conteúdo e todas as disciplinas que você vai cursar.
Informações do Curso
Veja a carga horária, duração e projeto pedagógico, além de outras informações.
Professores
Conheça os docentes do curso e suas qualificações.
Financiamentos e bolsas
Conheça as opções para viabilizar o seu curso na Univates.
Intercâmbio
Oportunidade para fazer intercâmbio em universidades parceiras em vários continentes.
Tour Virtual
Conheça os detalhes desta graduação e sua estrutura.
Converse conosco
Envie e receba mensagens através do e-mail da Univates, disponível para todos os alunos e egressos.
Gostaria de receber
novidades sobre o curso?
Onde você vai estudar
Laboratórios de Informática
Onde você vai estudar
Laboratório de Microbiologia
O Laboratório de Microbiologia dispões de materiais e equipamentos que possibilitam o desenvolvimento de diversas práticas microbiológicas, realizadas por professores e/ou alunos em aulas práticas, trabalhos de conclusão de curso, estágios curriculares e projetos de pesquisa, contando com um espaço para trinta e dois acadêmicos. O laboratório atende às disciplinas referentes às áreas de microbiologia, microbiologia ambiental, microbiologia clínica e microbiologia de alimentos. A área física do laboratório é dividida em uma sala de aula para atendimento aos alunos e respectivas atividades práticas, e uma sala para estoque de insumos.
Onde você vai estudar
Laboratório de Química Geral e Inorgânica
O Laboratório de Química Geral e Inorgânica possui espaço físico com capacidade para atender até 32 alunos. Conta com todo o acervo de materiais e equipamentos necessários para atender as disciplinas que envolvam operações básicas de laboratório e conceitos fundamentais de química, como análises estequiométricas e equilíbrio químico, preparo de soluções e atividades de síntese e análise inorgânica.
Onde você vai estudar
Laboratório de Química Orgânica
Este laboratório está equipado para atender até 32 alunos. Contando com maior número de capelas devido ao trabalho frequente com solventes tóxicos, possui equipamentos e materiais que possibilitam o desenvolvimento de reações simples, como transformações de grupos funcionais, e até bastante complexas que necessitam de várias etapas para serem concluídas, destilações etc.
Onde você vai estudar
Laboratório de Biologia Molecular
O Laboratório de Biologia Molecular desenvolve atividades práticas na área de Biologia Molecular, atendendo a cursos da área da Saúde. O Laboratório é equipado com aparelhos modernos utilizados para aulas práticas e pesquisas em nível de graduação e pós-graduação. O laboratório permite desde o isolamento de ácidos nucleicos à detecção de agentes patogênicos e marcadores moleculares. Atende a pesquisas nas áreas de Saúde e Alimentos.
Onde você vai estudar
Laboratório de Química Analítica
Este laboratório possui capacidade para 32 alunos, espaço onde são desenvolvidas análises qualitativas e quantitativas em alimentos, águas, solos, entre outros, e também manipulação de equipamentos analíticos. Nele também trabalham projetos de pesquisa da Instituição.
Onde você vai estudar
Laboratório Pesquisa IV
Este laboratório possui equipamentos mais específicos para análise de alimentos, bebidas e outros produtos processados industrialmente. A ocorrência das disciplinas que abordam essas áreas em dias diferentes possibilita a utilização da sala por ambas as áreas.
Onde você vai estudar
Laboratório de Química - Laboratório de Físico-Química e Operações Unitárias
Este laboratório, com capacidade para 24 alunos, é equipado para atender as disciplinas de Físico-Química. Os experimentos realizados neste espaço possibilitam a identificação de fenômenos químicos e físicos da matéria, proporcionando a aplicação da teoria à prática.
Onde você vai estudar
Laboratório de Química - Sala de Balanças
Esta sala é utilizada para procedimentos de pesagem que requerem maior confiabilidade e precisão de resultados, sendo usada como laboratório de apoio.
Onde você vai estudar
Laboratórios de Análises Clínicas - Laboratório de Bioquímica, Imunologia e Toxicologia
O Laboratório de Bioquímica e Imunologia conta com materiais e equipamentos que possibilitam a realização de diversas práticas laboratoriais. Entre elas, destacam-se dosagens de marcadores enzimáticos, glicose, colesterol, testes imunológicos (antígenos e anticorpos) e análises toxicológicas, como testes e dosagem de drogas. As atividades são realizadas por professores e/ou alunos durante aulas práticas, trabalhos de conclusão de curso e projetos de pesquisa. O espaço comporta até trinta e dois acadêmicos e atende às disciplinas relacionadas à bioquímica, imunologia, toxicologia, análises de líquidos corporais, raciocínio clínico e perícia criminal.
Onde você vai estudar
Laboratórios de Análises Clínicas - Laboratório de Parasitologia e Urinálise
O Laboratório de Parasitologia e Urinálise é equipado para diferentes tipos de análises, como exames parasitológicos de fezes, testes bioquímicos e microscópicos de urina e práticas de hematologia, incluindo coleta de sangue e análise de seus componentes. Além disso, o espaço permite atividades de preparação e análise de lâminas histológicas. As práticas são desenvolvidas por professores e/ou alunos durante aulas práticas, projetos de pesquisa e trabalhos de conclusão de curso. O ambiente tem capacidade para até trinta e dois acadêmicos e atende disciplinas nas áreas de parasitologia, líquidos corporais, hematologia e histologia.
Onde você vai estudar
Laboratórios de Análises Clínicas - Laboratório de Microscopia
O Laboratório de Microscopia é equipado com 32 microscópios, permitindo a visualização de lâminas de amostras preparadas pelos alunos. Conta também com um acervo de lâminas parasitológicas, hematológicas, histológicas e microbiológicas, que contribuem para o estudo de diversas disciplinas clínicas. O laboratório é utilizado por professores e/ou alunos em aulas práticas, trabalhos de conclusão de curso e projetos de pesquisa, com capacidade para trinta e dois acadêmicos.
Onde você vai estudar
Laboratório de Análise Instrumental/Sala de Apoio I
Esta sala abriga equipamentos para análise de substâncias por fotometria de chama, espectrofotometria, refratometria e ponto de fusão, servindo também como sala de apoio para outras disciplinas.
Onde você vai estudar
Laboratórios de Análises Clínicas - Laboratório de Microbiologia e Micologia
O Laboratório de Microbiologia e Micologia dispõe de materiais e equipamentos que permitem o desenvolvimento de diversas práticas microbiológicas, como o preparo de meios de cultura, cultivo de microrganismos e realização de testes para sua identificação e estudo. As atividades são realizadas por professores e/ou alunos em aulas práticas, trabalhos de conclusão de curso e projetos de pesquisa. O espaço tem capacidade para trinta e dois acadêmicos. O laboratório atende principalmente às disciplinas de bacteriologia e micologia, além de ser utilizado em práticas de esterilização de materiais.
Onde você vai estudar
Laboratório de Histologia, Microscopia e Luparia
O Laboratório de Histologia, Microscopia e Luparia dispõe de equipamentos e microscópios ópticos para até 45 alunos desenvolverem atividades práticas orientadas. Neste ambiente a comunidade acadêmica pode vivenciar na prática conteúdos pertinentes à área de estudo, possibilitando a análise, interpretação e ampliação de imagens de lâminas histológicas, microbiológicas, citológicas e parasitológicas, bem como a confecção de lâminas permanentes. Os equipamentos disponíveis no laboratórios também dão apoio para a realização de projetos de pesquisa e extensão, cursos de pós-graduação, podendo ser utilizados por alunos matriculados em disciplinas afins, para estudo extraclasse, estágios e trabalhos de conclusão.
Onde você vai estudar
Laboratório de Habilidades I - Anatomia Humana I
O laboratório de Anatomia Humana I é um espaço destinado para atividades práticas voltadas ao estudo anatômico dos diferentes sistemas orgânicos do corpo humano. Para tanto, os acadêmicos encontram cadáveres, peças biológicas além de recursos audiovisuais para uso em aulas. Conta com um espaço para atendimento de 36 acadêmicos.
Onde você vai estudar
Laboratório de Habilidades I - Anatomia Humana II
O Laboratório de Anatomia Humana II é um espaço localizado na sala 215 do prédio 8. Conta com 6 macas e área total de 71,47 m² para 36 alunos realizarem atividades orientadas por professor ou para estudos extra-classe. A área anexa aos laboratórios tem a finalidade de preparo de cadáveres e manutenção dos materiais já existentes, bem como o armazenamento dos mesmos.
Onde você vai estudar
Laboratório de Habilidades I - Laboratório de Modelos Anatômicos e Fisiologia Humana
O Laboratório de Modelos Anatômicos e Fisiologia Humana fornece um ambiente didático-prático para o estudo anatômico e fisiológico do corpo humano. Equipado com modelos anatômicos sintéticos e equipamentos/softwares que podem ser instalados para práticas de fisiologia humana, tem por objetivo favorecer o aprendizado dos alunos pertencentes aos diversos cursos da área da Saúde.
Onde você vai estudar
Laboratórios de Análises Clínicas - Sala de Hematologia
Onde você vai estudar
Centro Clínico Univates


O Laboratório de Microbiologia dispões de materiais e equipamentos que possibilitam o desenvolvimento de diversas práticas microbiológicas, realizadas por professores e/ou alunos em aulas práticas, trabalhos de conclusão de curso, estágios curriculares e projetos de pesquisa, contando com um espaço para trinta e dois acadêmicos. O laboratório atende às disciplinas referentes às áreas de microbiologia, microbiologia ambiental, microbiologia clínica e microbiologia de alimentos. A área física do laboratório é dividida em uma sala de aula para atendimento aos alunos e respectivas atividades práticas, e uma sala para estoque de insumos.

O Laboratório de Química Geral e Inorgânica possui espaço físico com capacidade para atender até 32 alunos. Conta com todo o acervo de materiais e equipamentos necessários para atender as disciplinas que envolvam operações básicas de laboratório e conceitos fundamentais de química, como análises estequiométricas e equilíbrio químico, preparo de soluções e atividades de síntese e análise inorgânica.

Este laboratório está equipado para atender até 32 alunos. Contando com maior número de capelas devido ao trabalho frequente com solventes tóxicos, possui equipamentos e materiais que possibilitam o desenvolvimento de reações simples, como transformações de grupos funcionais, e até bastante complexas que necessitam de várias etapas para serem concluídas, destilações etc.

O Laboratório de Biologia Molecular desenvolve atividades práticas na área de Biologia Molecular, atendendo a cursos da área da Saúde. O Laboratório é equipado com aparelhos modernos utilizados para aulas práticas e pesquisas em nível de graduação e pós-graduação. O laboratório permite desde o isolamento de ácidos nucleicos à detecção de agentes patogênicos e marcadores moleculares. Atende a pesquisas nas áreas de Saúde e Alimentos.

Este laboratório possui capacidade para 32 alunos, espaço onde são desenvolvidas análises qualitativas e quantitativas em alimentos, águas, solos, entre outros, e também manipulação de equipamentos analíticos. Nele também trabalham projetos de pesquisa da Instituição.

Este laboratório possui equipamentos mais específicos para análise de alimentos, bebidas e outros produtos processados industrialmente. A ocorrência das disciplinas que abordam essas áreas em dias diferentes possibilita a utilização da sala por ambas as áreas.

Este laboratório, com capacidade para 24 alunos, é equipado para atender as disciplinas de Físico-Química. Os experimentos realizados neste espaço possibilitam a identificação de fenômenos químicos e físicos da matéria, proporcionando a aplicação da teoria à prática.

Esta sala é utilizada para procedimentos de pesagem que requerem maior confiabilidade e precisão de resultados, sendo usada como laboratório de apoio.

O Laboratório de Bioquímica e Imunologia conta com materiais e equipamentos que possibilitam a realização de diversas práticas laboratoriais. Entre elas, destacam-se dosagens de marcadores enzimáticos, glicose, colesterol, testes imunológicos (antígenos e anticorpos) e análises toxicológicas, como testes e dosagem de drogas. As atividades são realizadas por professores e/ou alunos durante aulas práticas, trabalhos de conclusão de curso e projetos de pesquisa. O espaço comporta até trinta e dois acadêmicos e atende às disciplinas relacionadas à bioquímica, imunologia, toxicologia, análises de líquidos corporais, raciocínio clínico e perícia criminal.

O Laboratório de Parasitologia e Urinálise é equipado para diferentes tipos de análises, como exames parasitológicos de fezes, testes bioquímicos e microscópicos de urina e práticas de hematologia, incluindo coleta de sangue e análise de seus componentes. Além disso, o espaço permite atividades de preparação e análise de lâminas histológicas. As práticas são desenvolvidas por professores e/ou alunos durante aulas práticas, projetos de pesquisa e trabalhos de conclusão de curso. O ambiente tem capacidade para até trinta e dois acadêmicos e atende disciplinas nas áreas de parasitologia, líquidos corporais, hematologia e histologia.

O Laboratório de Microscopia é equipado com 32 microscópios, permitindo a visualização de lâminas de amostras preparadas pelos alunos. Conta também com um acervo de lâminas parasitológicas, hematológicas, histológicas e microbiológicas, que contribuem para o estudo de diversas disciplinas clínicas. O laboratório é utilizado por professores e/ou alunos em aulas práticas, trabalhos de conclusão de curso e projetos de pesquisa, com capacidade para trinta e dois acadêmicos.

Esta sala abriga equipamentos para análise de substâncias por fotometria de chama, espectrofotometria, refratometria e ponto de fusão, servindo também como sala de apoio para outras disciplinas.

O Laboratório de Microbiologia e Micologia dispõe de materiais e equipamentos que permitem o desenvolvimento de diversas práticas microbiológicas, como o preparo de meios de cultura, cultivo de microrganismos e realização de testes para sua identificação e estudo. As atividades são realizadas por professores e/ou alunos em aulas práticas, trabalhos de conclusão de curso e projetos de pesquisa. O espaço tem capacidade para trinta e dois acadêmicos. O laboratório atende principalmente às disciplinas de bacteriologia e micologia, além de ser utilizado em práticas de esterilização de materiais.

O Laboratório de Histologia, Microscopia e Luparia dispõe de equipamentos e microscópios ópticos para até 45 alunos desenvolverem atividades práticas orientadas. Neste ambiente a comunidade acadêmica pode vivenciar na prática conteúdos pertinentes à área de estudo, possibilitando a análise, interpretação e ampliação de imagens de lâminas histológicas, microbiológicas, citológicas e parasitológicas, bem como a confecção de lâminas permanentes. Os equipamentos disponíveis no laboratórios também dão apoio para a realização de projetos de pesquisa e extensão, cursos de pós-graduação, podendo ser utilizados por alunos matriculados em disciplinas afins, para estudo extraclasse, estágios e trabalhos de conclusão.

O laboratório de Anatomia Humana I é um espaço destinado para atividades práticas voltadas ao estudo anatômico dos diferentes sistemas orgânicos do corpo humano. Para tanto, os acadêmicos encontram cadáveres, peças biológicas além de recursos audiovisuais para uso em aulas. Conta com um espaço para atendimento de 36 acadêmicos.

O Laboratório de Anatomia Humana II é um espaço localizado na sala 215 do prédio 8. Conta com 6 macas e área total de 71,47 m² para 36 alunos realizarem atividades orientadas por professor ou para estudos extra-classe. A área anexa aos laboratórios tem a finalidade de preparo de cadáveres e manutenção dos materiais já existentes, bem como o armazenamento dos mesmos.

O Laboratório de Modelos Anatômicos e Fisiologia Humana fornece um ambiente didático-prático para o estudo anatômico e fisiológico do corpo humano. Equipado com modelos anatômicos sintéticos e equipamentos/softwares que podem ser instalados para práticas de fisiologia humana, tem por objetivo favorecer o aprendizado dos alunos pertencentes aos diversos cursos da área da Saúde.


Vantagens de estudar aqui
Possibilidades no mercado de trabalho
Primeiro curso do País com habilitação em ênfase imagenologia.
Vantagens de estudar aqui
Infraestrutura diferenciada
Estudantes têm a oportunidade de interagir (em estágios e aulas práticas) com os serviços do Saúde Univates (laboratórios de análises clínicas, biologia molecular, entre outros).
Vantagens de estudar aqui
Currículo inovador
Curso baseado em projetos integradores, que incentivam a capacitação técnica interdisciplinar e a prática ao longo de toda a formação.
Vantagens de estudar aqui
Biomedicina na prática
Disciplinas com vivências na comunidade, aplicando diversas habilitações do curso.

Primeiro curso do País com habilitação em ênfase imagenologia.

Estudantes têm a oportunidade de interagir (em estágios e aulas práticas) com os serviços do Saúde Univates (laboratórios de análises clínicas, biologia molecular, entre outros).
Curso baseado em projetos integradores, que incentivam a capacitação técnica interdisciplinar e a prática ao longo de toda a formação.

Disciplinas com vivências na comunidade, aplicando diversas habilitações do curso.

Reinvenção do ensino
A nova graduação da Univates une a qualidade de uma das melhores universidades privadas do Brasil a uma proposta curricular inovadora e exclusiva. Os cursos são divididos em blocos curriculares, que integram as vivências do ensino presencial e a flexibilidade do ensino a distância.

Mais qualidade
O programa de ensino foi concebido pelos mestres e doutores da nossa Universidade, organizados em diferentes grupos de trabalho. De forma colaborativa, garantem a articulação entre os componentes dos blocos curriculares.

Mais flexibilidade
O estudante não precisa vir para a Univates todos os dias da semana em que tiver aula. A proposta híbrida é única e cada curso de graduação presencial pode ser composto de até 40% da carga horária na modalidade a distância.

Mais vivências
Os ateliers e seminários serão realizados na Univates, promovendo a interação constante entre estudantes e professores. As atividades práticas continuarão acontecendo em modernos laboratórios, equipados com alta tecnologia.

Mais dinâmica
A partir dos princípios da Aula+, os estudantes contam com formação de excelência e cada vez mais voltada às demandas do mercado de trabalho contemporâneo e ao desenvolvimento regional.
Biomedicina
Curso de Graduação | Bacharelado- Presencial
- Noturno
- 4 anos e meio

